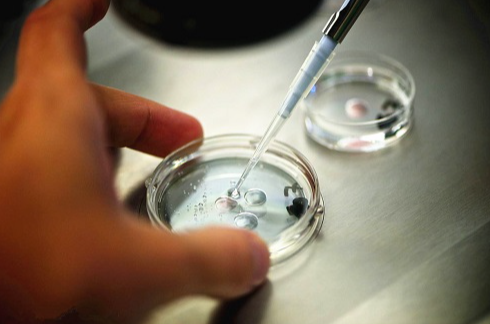

2026广州试管成功率高的医院排行榜前十名新鲜出炉
在辅助生殖技术日益成熟的今天,试管婴儿技术已成为众多不孕不育家庭实现生育梦想的重要途径。广州,作为华南地区的医疗中心,汇聚了众多在试管婴儿领域技术领先、经验丰富的医院。近日,根据2026年的最新数据及患者口碑,广州试管成功率高的医院排行榜前十名新鲜出炉,为有需求的家庭提供了权威参考。

广州高成功率试管婴儿医院
1、中山大学附属第一医院
中山大学附属第一医院生殖医学中心是国内较早开展试管婴儿技术的医疗机构之一,拥有30余年的历史沉淀。该中心配备国际认证的胚胎实验室,年完成试管周期超5000例,临床妊娠率高达50%-60%,尤其在复杂遗传疾病筛查、地中海贫血基因诊断等领域成果显著。其三代试管婴儿技术(PGT)成功率稳居国内前列,是疑难病例的首选医院。
2、广州医科大学附属第三医院
广州医科大学附属第三医院生殖中心是华南地区规模较大的辅助生殖机构之一,三代试管成功率稳定在55%-65%。该中心在男性不育症诊治领域处于领先地位,针对弱精症、无精症患者开发了显微取精技术,帮助众多家庭实现生育梦想。其“多学科协作”模式为复杂病例提供了综合解决方案,备受患者好评。
3、广东省妇幼保健院
广东省妇幼保健院生殖医学中心在三代试管技术上表现突出,PGD和PGS临床妊娠率分别达68%和62%。该中心擅长高龄女性试管治疗,针对卵巢功能衰退、反复移植失败等难题积累了丰富经验。其“全周期管理”模式涵盖心理疏导、营养指导等增值服务,患者满意度较高,是追求高品质服务家庭的首选。
4、中山大学孙逸仙纪念医院
中山大学孙逸仙纪念医院生殖医学中心以“全生命周期生殖健康管理”为特色,三代试管技术结合遗传咨询,为遗传病家庭提供从筛查到干预的全链条服务。该中心试管婴儿成功率稳定在52%左右,与国内外实验室合作紧密,技术更新速度较快,是遗传病家庭的优选医院。
5、广州市妇女儿童医疗中心
广州市妇女儿童医疗中心是华南地区少数能同时开展一、二、三代试管技术的专科医院,卵子保存技术临床妊娠率达60%。针对多囊卵巢综合征、卵巢早衰等女性生育难题,该中心研发了个性化促排方案,成功率显著提升。其家庭友好型诊疗环境和一站式服务流程备受年轻夫妇青睐。
6、南方医科大学南方医院
南方医科大学南方医院生殖中心以“医疗创新”为核心,在多囊卵巢综合征、子宫内膜异位症等疾病的试管治疗中成效显著。该中心引入AI辅助胚胎筛选系统,胚胎着床率提升15%。其军民融合背景赋予了技术迭代速度快的优势,患者反馈其费用透明、服务周到。
7、中山大学附属第六医院
中山大学附属第六医院生殖医学中心可开展一代、二代、三代试管婴儿技术,试管婴儿成功率保持在55%以上。该中心拥有专业的医护团队和先进的实验室设备,为患者提供全面的诊疗服务。其丰富的临床经验和全面的技术服务赢得了患者的广泛认可。
8、广东省计划生育专科医院
广东省计划生育专科医院生殖医学中心在试管婴儿领域积累了丰富的经验,试管婴儿成功率达55%以上。该中心注重患者个体差异,制定个性化的治疗方案,取得了良好的治疗效果。其费用相对较低,性价比高,适合预算有限的家庭。
9、广州中医药大学第一附属医院
作为全国知名的中西医结合生殖医学中心,广州中医药大学第一附属医院将传统中医调理与现代辅助生殖技术结合,针对反复移植失败、薄型子宫内膜患者开发了针灸、中药辅助方案,移植成功率提升10%-15%。其“自然疗法+试管”模式吸引了众多追求绿色医疗的家庭。
10、广州市番禺区何贤纪念医院
广州市番禺区何贤纪念医院生殖医学中心在番禺区乃至周边地区享有较高声誉,试管婴儿成功率保持在50%以上。该中心拥有经验丰富的专家团队和先进的实验室设备,为患者提供高质量的试管婴儿治疗服务。其区域领先地位和服务基层的理念赢得了患者的广泛赞誉。
广州试管成功率高的医院排行榜前十名的出炉,为有需求的家庭提供了权威参考。然而,选择医院时,除了考虑成功率外,还应结合自身情况、医院资质、医生经验、治疗方案等因素综合考虑。希望每一位不孕不育患者都能找到适合自己的医院,早日实现生育梦想。
文章更新时间:2026-01-2416:52:54
交流群
位姐妹
高龄/绝经试管
助孕攻略群
群
位姐妹
不孕不育
助孕经验群
群
位姐妹
染色体异常
备孕交流群
群
位姐妹
三代/四代试管
助孕交流群
群